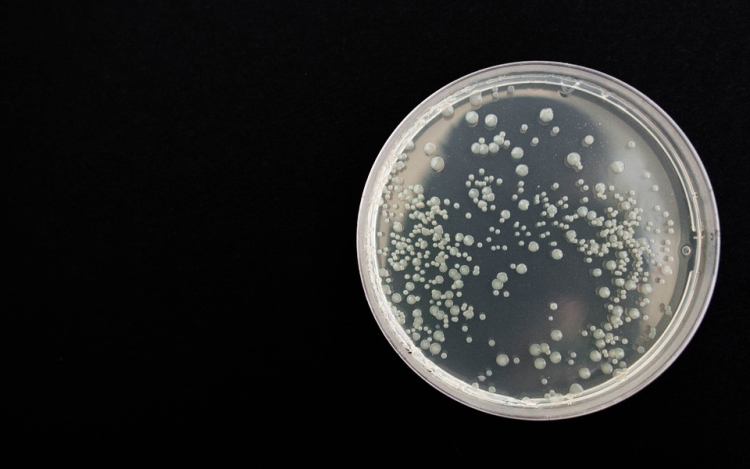

Hírek
2020. Június 18. 17:02, csütörtök |
Életmód
Forrás: mti - illusztráció: pixabay
A felmelegedéssel több baktériumfertőzés várható
A globális felmelegedéssel több olyan fertőzéses megbetegedés várható, melyet a vibrió elnevezésű, pálca alakú baktériumok okoznak – állapította meg egy német kutatócsoport.
A tengerek és a folyótorkolatok vizének melegedése elősegíti a sót jól tűrő baktériumok terjedését a német szövetségi kockázatértékelési kutatóintézet (BfR) értékelése szerint.
„Húsz Celsius-fok fölött gyorsabban szaporodnak a vibriók, különösen a Balti-tengerben nőhet a veszély, amely eddig hűvösebb volt” – mondta Eckhard Strauch, az intézet vibriókutató részlegének vezetője.
Hosszabb hőhullámoknál a vízhőmérséklet 20 fok fölé emelkedhet, tehát javulnak a vibriók életfeltételei, ráadásul a Balti-tenger sókoncentrációja alacsony. „Éppen a két veszélyes faj, a Vibrio vulnificus és a Vibrio cholerae non-O1 számára javulnak a feltételek” – tette hozzá. A vibriók az egész Baltikumban, valamint az északi-tengeri folyótorkolatokban is elterjedtek.
A Meteorológiai Világszervezet (WMO) az év eddigi hónapjai alapján végzett értékelése szerint új hőmérsékleti rekordok születhetnek idén, az északi féltekén ismét forró nyár várható.
A Robert Koch Intézet szerint fiatal, egészséges felnőttek ritkán betegednek meg vibriófertőzéstől, idősebb vagy legyengült immunrendszerű emberekre azonban veszélyt jelent: főként a cukorbetegek, a májbajosok és a daganatosok kockázata jelentős.
Halálos kimenetelű fertőzés egyébként elvétve akadt az elmúlt években, a betegséget antibiotikummal kezelik.
Ezek érdekelhetnek még
2026. Június 19. 14:00, péntek | Életmód
Bóna Szabolcs: a klímaváltozás már nem a jövő, hanem a jelen kihívása
Az idei év ismét emlékeztet bennünket arra, hogy a klímaváltozás már nem a jövő, hanem a jelen kihívása - jelentette ki Bóna Szabolcs agrár- és élelmiszergazdaságért felelős miniszter Facebook-bejegyzésében csütörtökön.
2026. Június 18. 15:00, csütörtök | Életmód
Magyarország csatlakozott az erdők védelmét célzó európai kezdeményezéshez
Magyarország csatlakozott az erdők védelmét célzó európai kezdeményezéshez - közölte az Élő Környezetért Felelős Minisztérium (ÉKFM) szerdán az MTI-vel.
2026. Június 17. 13:00, szerda | Életmód
Erdő Péter fogadta Magyar Pétert
Erdő Péter bíboros, prímás esztergom-budapesti érsek fogadta Magyar Péter miniszterelnököt a budapesti prímási palotában - tudatta a főegyházmegye kedden a Facebook-oldalán.
2026. Június 16. 16:00, kedd | Életmód
Fotókiállítás a Hungaroring 40 évvel ezelőtti megnyitójának emlékére
Jubileumi fotókiállítás látható hétfőtől a budai Millenáris Parkban abból az alkalomból, hogy 40 éve a Drapál János Emlékversennyel ezen a napon nyílt meg a Forma-1-es Magyar Nagydíj helyszíne, a Hungaroring.
